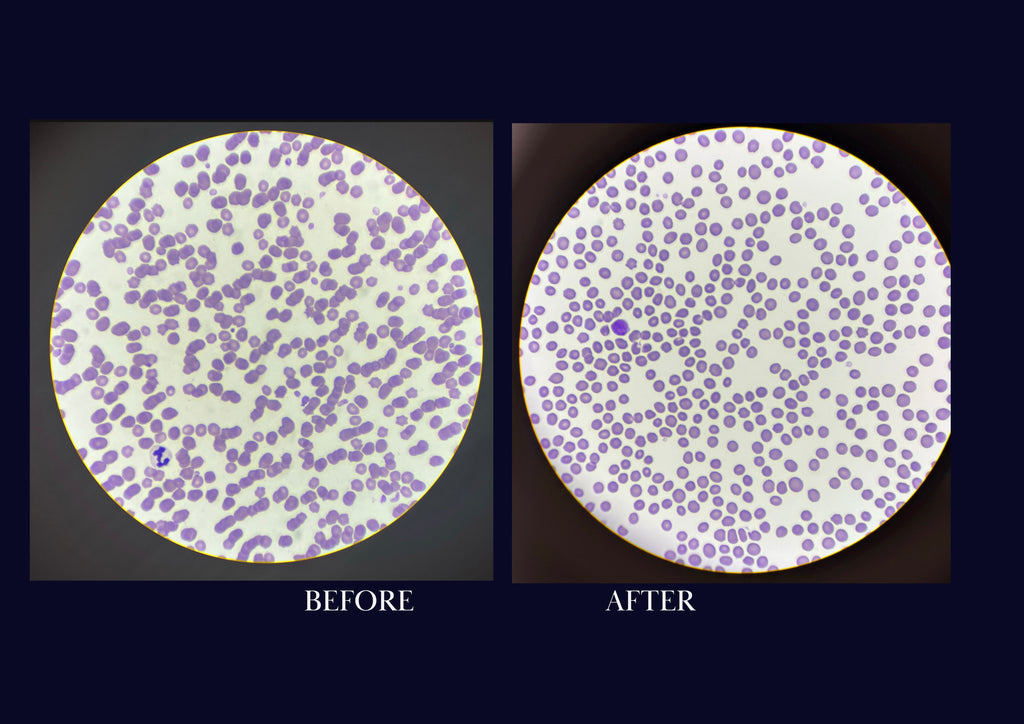
Complete Formula, ( without garlic )

30 Day Transformation
The amazing short transformation of this 20yr old pole and barrel horse.
This gelding showed a full body transformation, gained weight, better coat conditioned and he felt more energize.

Description
30 day serving. Without garlic option. Just $2.50 a day before postage, for an overall supplement.
Complete is an all in ONE balanced supplement!!
Designed so you won’t need to feed multiple products, just one scoop a day has everything your horse needs.
Complete is the total body supplementation that’s proven to rebuild cells, it’s packed with minerals and vitamins and is very anti-inflammatory, it helps the body to heal, recover and stay balanced, to keep your horse sound and feeling great.
Active Ingredients:
Pink Himalayan Salt, Methylsulfonylmethane (MSM), Nettle, Ginger, Rosemary, Turmeric, Magnesium Citrate, Nicotinamide Mononucleotide (NMN), Peppercorn, Diatomaceous Earth (DE).
No Fillers or Stabilizers
Proven benefits consist of:
Immune support
Gut health
Bone health
Joint support
Antifungal
Anti parasitic
Anti Inflammatory
Skin & Coat health
Cell repair
Circulation
Healthy Weight, Cool calories
Calming
Hoof health
Increase Healing
Each ingredient is carefully measured out to the very ounce, to help activate each other’s healing properties. So your horse gets the full benefits of this supplementation.
Our goal here at Cellular Equine is to give horses the healthy lives they deserve.